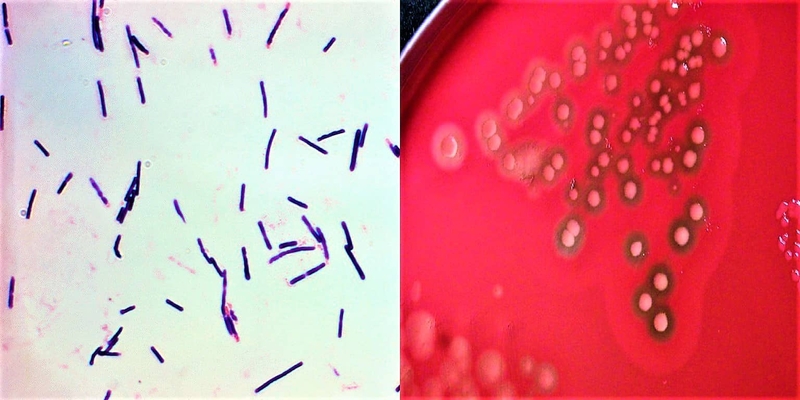
Viêm ruột hoại tử do Clostridial: Triệu chứng và điều trị 2

Dược sĩ Đại học có nhiều năm kinh nghiệm trong việc tư vấn Dược phẩm và hỗ trợ giải đáp thắc mắc về Bệnh học. Hiện đang là giảng viên cho Dược sĩ tại Nhà thuốc Long Châu.
Chí Doanh
10/01/2024
Mặc định
Lớn hơn
Viêm ruột hoại tử do Clostridial là một trong những bệnh về đường tiêu hóa nghiêm trọng và đe dọa tính mạng nếu không được phát hiện, đặc biệt là ở trẻ sơ sinh. Bệnh có triệu chứng như thế nào, điều trị ra sao? Hãy cùng Long Châu tìm hiểu qua bài viết dưới đây.
Viêm ruột hoại tử là bệnh đường tiêu hóa mắc phải phổ biến nhất ở trẻ sinh non và trẻ sơ sinh, với tỷ lệ tử vong cao. Nguyên nhân chủ yếu đến từ việc nhiễm chủng Clostridial. Bài viết này sẽ chia sẻ cho bạn một số thông tin cơ bản về Clostridial, con đường lây nhiễm, triệu chứng và cách chữa trị viêm ruột hoại tử do Clostridial.
Clostridium perfringens (một trong các chủng Clostridial) thuộc họ Clostridiaceae là một loại trực khuẩn gram dương kỵ khí, hình que, có thể hình thành bào tử khi môi trường bất lợi. Tuy nhiên, nó vẫn có thể tồn tại trong môi trường hiếu khí (tức là khả năng chịu oxy), tạo ra khí độc và phát triển nhanh chóng. Do đó, nó có khả năng tác động đến nhiều loại nhiễm trùng gây độc cho mô ở người, bao gồm viêm ruột hoại tử, hoại tử vết thương bị nhiễm trùng (hoại thư khí), viêm dạ dày - ruột (bao gồm tiêu chảy do thực phẩm và không phải do thực phẩm) ở người trưởng thành.
C. perfringens có mặt ở môi trường rất đa dạng bao gồm mặt đất, thực phẩm, nước thải và là một trong số hàng nghìn loại vi khuẩn đường tiêu hóa (hệ vi sinh vật đường ruột) của cả người và động vật khỏe mạnh cũng như mắc bệnh. Điều đặc biệt hơn là C. perfringens có thể phát triển nhân lên nhanh chóng trong môi trường tối ưu, 12 - 17 phút ở 37°C. Thời gian sinh sôi nhanh hơn cả vi khuẩn hội sinh trong đường ruột như Escherichia coli, dẫn đến sự xâm chiếm ruột hiệu quả và gây nhiễm trùng ruột.
Về mặt lâm sàng, C. perfringens liên quan đến nhiều bệnh đường ruột và hệ thống nghiêm trọng như đã kể trên. Điều quan trọng giúp chúng làm được như vậy là do các chủng C. perfringens có thể tiết ra hơn 20 độc tố hoặc enzyme đã được xác định có khả năng là yếu tố độc lực chính liên quan đến sinh lý bệnh. Một số độc tố do C. perfringens tạo ra gây bệnh ở người bao gồm:

Là một loài kỵ khí chịu được hiếu khí, C. perfringens có khả năng tồn tại trong môi trường hiếu khí chẳng hạn như trên các bề mặt trong khu bệnh viện và gây ra sự phát triển bệnh trong môi trường ưa khí (tức là ruột người lớn/trẻ sơ sinh non tháng) và thêm vào đó là oxy, các mô bị phơi nhiễm (chẳng hạn như hoại thư do khí), có thể tạo điều kiện thuận lợi cho vi khuẩn lây truyền từ người này sang người khác.
C. perfringens tồn tại ở dạng bào tử giúp nó có thể tồn tại trong điều kiện khắc nghiệt hoặc thiếu chất dinh dưỡng. Đặc điểm hình thành bào tử này đóng một vai trò quan trọng trong việc phân tán vi khuẩn này từ các môi trường khác nhau đến vật chủ. Bào tử C. perfringens có thể tồn tại ở nhiệt độ nấu bình thường. Vì vậy, nó có thể sinh sôi nảy nở trong thực phẩm được bảo quản không đúng cách. Sự bùng phát thường liên quan đến việc hâm nóng thức ăn qua đêm hoặc hâm nóng nước thịt, thịt gia cầm không đúng cách. Ngoài ra, những người thiếu máu cục bộ đường ruột, nhiễm ký sinh trùng và trẻ sinh non có nguy cơ viêm ruột hoại tử do Clostridial cao hơn.

Các triệu chứng ngộ độc thực phẩm do C. perfringens khởi phát sau khi ăn thịt sống hoặc nấu chưa chín từ 8 đến 16 giờ. Bệnh nhân thường bị chướng bụng, co thắt ruột dẫn đến đau bụng lan tỏa, tiêu chảy nhiều nước, có thể kèm máu, có/không sốt và nôn mửa.
C. perfringens cũng có liên quan đến tiêu chảy không do thực phẩm như tiêu chảy do dùng kháng sinh. Triệu chứng lâm sàng như đau bụng, tiêu chảy kéo dài (trên 3 ngày đến vài tuần) và phân có máu. Bệnh nhân bị tiêu chảy dùng kháng sinh phổ rộng có thể tiến triển nặng do mất nước khi tiêu chảy và có thể tiến triển thành viêm đại tràng. Tuy nhiên, bệnh có thể hồi phục hoàn toàn sau điều trị.

Hầu hết các trường hợp ngộ độc thực phẩm và bệnh tiêu chảy không do thực phẩm đều có ít hoặc không có biến chứng nếu xử lý kịp thời. Việc không chữa trị có thể dẫn đến nhiễm trùng máu với biểu hiện hạ huyết áp, nhịp tim nhanh, sốc nhiễm trùng và thủng hoặc hoại thư đường ruột.
Nhiễm C. perfringens thường là một bệnh lành tính, bệnh nhân có tình trạng lâm sàng nhẹ có thể tự khỏi sau khi truyền dịch hồi sức để duy trì trạng thái thể tích bình thường và bổ sung men vi sinh để cân bằng lại hệ khuẩn ruột. Tuy nhiên, những bệnh nhân có tình trạng lâm sàng nặng (đặc biệt là trẻ sinh non), sốc nhiễm trùng kèm theo hoại tử cơ thì sẽ cần dùng kháng sinh, hỗ trợ huyết áp và can thiệp phẫu thuật nếu có dấu hiệu thủng, hoại tử ruột. Các kháng sinh có thể dùng trong trường hợp viêm ruột hoại tử như ampicillin, vancomycin, amikacin hay metronidazole,... tùy vào mô hình kháng thuốc tại vùng sinh sống.

Tóm lại, Clostridium perfringens gây nhiễm trùng đường tiêu hóa cấp tính ở mức độ nghiêm trọng từ tiêu chảy đến viêm ruột hoại tử. Hầu hết ngộ độc thực phẩm và các bệnh tiêu chảy không do thực phẩm từ C. perfringens bắt nguồn từ việc ăn phải thịt nấu chưa chín kỹ. Vì vậy, an toàn thực phẩm là điều cần thiết để ngăn ngừa và hạn chế sự lây lan của bệnh tật.
Dược sĩ Đại họcNguyễn Mỹ Huyền
Dược sĩ Đại học có nhiều năm kinh nghiệm trong việc tư vấn Dược phẩm và hỗ trợ giải đáp thắc mắc về Bệnh học. Hiện đang là giảng viên cho Dược sĩ tại Nhà thuốc Long Châu.